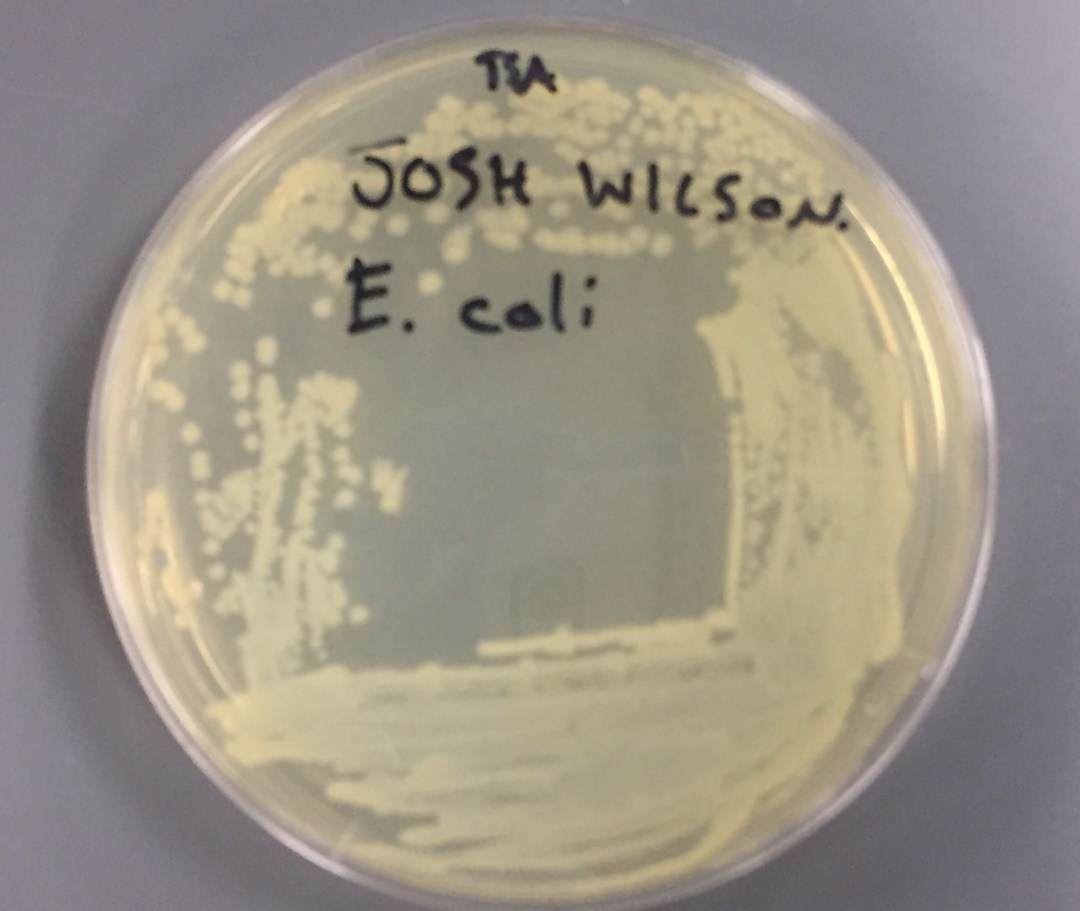
img_1719-1

Had the idea to look at some epithelial cells swabbed from inside my cheek, tonight under the microscope. I am not a histologist, and so I can’t really identify much beside the large nuclei, but they are still pretty cool to look at nonetheless.
Blog
How to Make Bar Soap (Cold Process)
In this video, I show you how to make bar soap using the cold process. This is an updated version of the previous video I posted showing how it lathers up. This was the first attempt with the formula I used and it worked great. The only thing I’d change is adding more fragrance. I wasn’t sure how much I would need but the next batch I make, I’ll double or triple the amount I used.
How to Make Ethanol (Fermentation)
This is the first of two videos on how to ferment and distill ethanol at home. Ethanol is used as a chemical solvent and is very useful in many laboratory reactions. As well, I will be using it to extract fragile oils and act as a carrier for my perfumes. This video shows how to set up for a sugar fermentation of ethanol and the next video will show me distilling off and further purifying the ethanol with molecular sieves.
Bacteria Metabolisms! Cool Stuff.
In this lab, we determined the metabolic capabilities of several bacteria. Using OF, Urease, Red Broth, Catalase, and Oxidative tests we were able to say what bacteria we were looking at. Bacteria have a wide range of abilities when it comes to metabolisms. Obviously, we aren’t able to culture and play with rare varieties that utilize super crazy stuff, but these were fun nonetheless and we all learned something.
Bacteriophage Culture w/ E. coli
Last week in microbiology lab we cultured bacteriophages in this experiment. I filmed most of the process for review and uploaded it to YouTube. The T4 phages infect the E. coli cells and hijack their cellular machinery to replicate themselves. Once enough Progeny viruses have been replicated, they burst through the cell wall, lysing it. This will show up on an agar plate as a translucent spot where no bacteria is growing. After performing a serial dilution of our bacteriophage solution we transferred to the E. coli vials and incubated for 24 hours. The next day there were clearly plaques where the phages have killed E. coli cells.
Spider Mites? Rose Petal Pests
Found these crawling over my miniature rose bush and they look like spider mites but I’m not sure. I’ll have to look them up but thought they looked cool under the microscope despite giving my plant disease! Some of the leaves are spotting as if infected by a virus and these guys are suspect vectors. Any thoughts on how to get rid of them?
Yogurt is Alive! Bacteria under Light Microscope
After a delicious snack, I decided to check out what bacteria looked like in my yogurt. It appears to be at least two different cocci species but I haven’t researched possible ones yet.
Motile Bacteria in Culture
Today after lecture we went to the lab to check the results of our motile test. We had previously inoculated a medium solution in test tubes with both E. coli and S. aureus. We wanted to see whether after incubation they would move from the initial site of transfer, throughout the media. Here are pics of our results:


Clearly, the E. coli is able to move about much more freely than the S. aureus on the left, which is interesting because I read that E. coli don’t normally produce flagella in culture but only in nature as they have to search more for their nutrients. So I wonder what makes them so much more motile. Also below is included a pic of our E. coli inoculum for good measure:
Staphylococcus aureus Under Microscope
Today in Microbiology Lab we reviewed how to maximize the potential of a light microscope for viewing specimens and looked at bacteria, yeast, and zooplankton. Here are some pictures I tried to get at the few we looked at:
The largest picture is Staphylococcus aureus, a Gram-positive bacteria and a member of Firmicutes. Top right is zooplankton viewed with a dark field microscope, which was pretty cool as I’ve never seen one before and the dark background really makes the details pop. Middle left is another view of S. aureus at I believe it was 100x magnification. It looked totally different from the picture on the left viewed at a closer magnification. The bottom left is Escherichia coli, which was so small!
We learned how to use a stage micrometer which despite the name is actually found on a blank slide, go figure. And we used this after we calibrated the ocular micrometer to measure the width and length of these things. The E. coli was so tiny I could barely guess an estimate. We decided on less than .5 μm width and about 1 μm length. I have yet to look these up to see how accurate these are, however.
Still, a pretty cool lab though and I learned how I can utilize my personal microscope better. : ) Thanks, Dr. Brooks!
Garden Update 8/30/18
Almost a month has past since my last garden update. Honestly I haven’t been doing much there except for swinging by every other week it seems and picking ripe peppers and lettuce. Today after church however, we decided to stop by on our way home so I wouldn’t have to go back another day this week. Haha Look at the spoils!

I was surprised to see my tomatoes have grown bigger. There’s one plant that has started ripening its fruit already despite them being super small, and I was thinking the others would follow suite. All three of the plants I sowed were Early Girls, but the other two, I was happy to see have begun ripening fruit that’s worthy of picking. So we got two. The others will be ripe soon enough though and when they are, I’ll have a lot of them! Carrots finally looked big enough to pull. Some of them at least. I’ve been waiting patiently for them forever it seems. When I sowed them, I put a few seeds into each hole placed about 2″ apart and as a result some of them have grown together into one root. It’s no matter, but makes them look like molars than long pointed carrots. 
We picked the last of the butter leaf lettuce. I’m thinking I’ll have time to sow some more and get more before summer is over. Gypsy peppers were the most beautiful I’ve picked yet, with all varieties of color. I decided to pick some mint as we intended to give a lot of this away to friends and since the plant is so large and we needed to trim it down, I thought, why not? I decided to keep some as well and try my luck at making a tea from it. 



